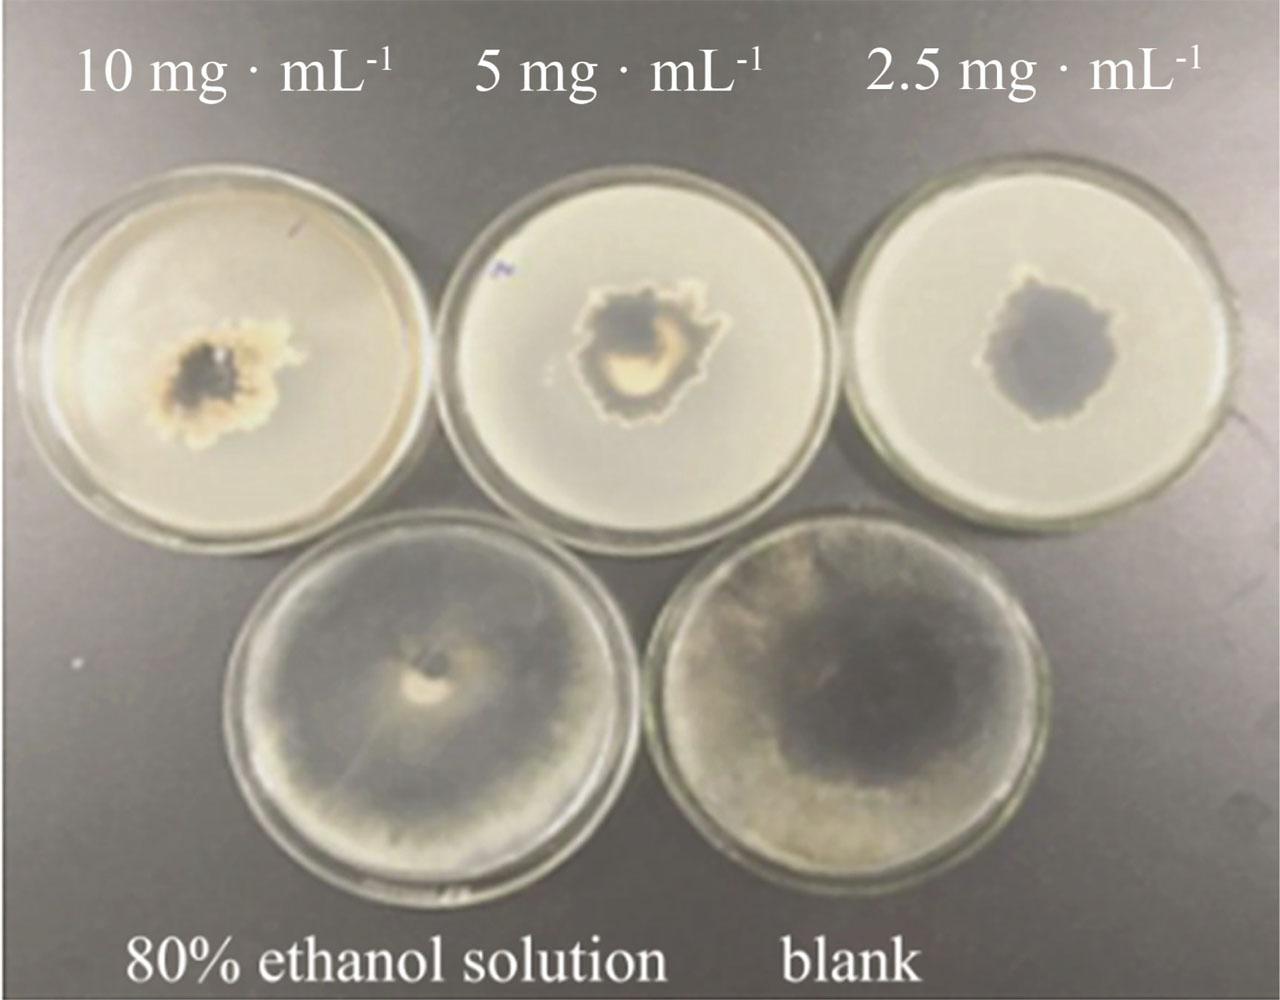

Ginkgo biloba has been widely planted since the 1990s as an important economic tree with medicinal value. As early as Ancient China, there are records of using ginkgo nuts as medicine. At present, G. biloba extract has become one of the most popular herbal supplements in the world.
The testa is the fleshy part that wraps around the hard shell of ginkgo (G. biloba) seeds, and it contains many active ingredients, such as biflavone, alkyl phenol and phenolic acids, sterols and steroids, palmitone, catechol, amino acids, sugars and so on (Sun et al., 2012). These active ingredients have the functions of capturing free radicals and anti-platelet activation factors, in addition to promoting blood circulation and brain metabolism (Yang et al., 2004a, 2004b).
Ginkgolic acid is a kind of natural plant antifungal substance found in the testa of G. biloba with important bioactivity (Hua et al., 2017). It contains hydroginkgolic acid, hydroginkgolinic acid, ginkgoneolic acid and so on (Ndjoko et al., 2000). It has many effects, such as anti-oxidation, anti-inflammation, anti-tumour, anti-allergy, antibacteria, in addition to prevention and control of diseases and pests. Ginkgolic acid (C15:1 and C17:1) at 5 μg · mL-1 and G. biloba extract at 100 μg · mL-1 significantly inhibited Escherichia coli biofilm formation on the surfaces of polystyrene and glass, and on nylon membranes (Lee et al., 2014).
Nigrospora oryzae is a well-known saprotroph on many plant species and has been mentioned as a pathogen on many hosts (Wright et al., 2008). A survey of the literature revealed that infection due to N. oryzae could cause leaf spot, blight and blight symptoms, in addition to seriously harming the growth of plants (Abass et al., 2013). N. oryzae has caused a great deal of damage to agricultural production. N. oryzae infection has been found in commercial tea plantations in Darjeeling, India, which reduced the yield and quality of tea (Dutta et al., 2015). In addition, N. oryzae has been reported as a pathogen of sesame leaf blight in Pakistan (Rehman et al., 2021).
Epipremnum aureum is an herbaceous evergreen with a strong ability to purify air and has been widely used as an important foliage plant for indoor greening (Aydogan and Montoya, 2011). Unfortunately, it is susceptible to multiple pathogens, such as Colletotrichum gloeosporioides, Cylindrocladium colhounii, N. oryzae and so on; it develops leaf spot, root rot or other diseases in the growing process.
Ginkgolic acid has been proven to inhibit the growth and reproduction of a variety of pathogenic microorganisms, but the pathway and mechanism of this effect have been seldom reported. In this work, the inhibitory activities of ginkgolic acid against N. oryzae was investigated and its inhibitory mechanism was studied. At the same time, protection of E. aureum plant leaves infected by N. oryzae through the action of ginkgolic acid was also investigated.
N. oryzae, Alternaria alternata and Penicillium expansum were stored in the Microbiological Culture Collection Centre of Dalian Polytechnic University, China. These pathogenic fungi were maintained on potato dextrose agar (PDA: extract of boiled potatoes, 5 g; anhydrous glucose, 20 g; agar, 20 g; and distilled water, 1,000 mL) stored at 4 °C and activated by inoculating on a PDA plate and cultured at 28 °C for 4 d before the experiment.
The chemicals used in the culture medium were of reagent grade; other chemicals were of analytical grade. The kits (superoxide dismutase [SOD], A001-3; catalase [CAT], A007-1) used to measure SOD and CAT were purchased from the Nanjing Jiancheng Bioengineering Institute, Nanjing, Jiangsu, China. Ginkgolic acid standard was purchased from Shanghai Tauto Biotech Co., Shanghai, China.
Ginkgo fruits (G. biloba L. cv. ‘Luanguofoshou’) were harvested at a mature stage from a special garden base in Dalian, Liaoning, China (longitude: 121°57′, latitude: 38°95′). All rotten or visibly damaged fruits were removed to obtain seeds; then, the testae were air-dried at room temperature. We then washed the G. biloba testa, dried it to a constant weight, crushed it and sifted it. Crude ginkgolic acid was extracted according to the method reported by Hausen (1998). Briefly, the powder was reflux-extracted with 80% ethanol (solid–liquid ratio of 1:20) at 80 °C for 3 h. Then, the mixture was centrifuged; the supernatant was concentrated and freeze-dried to obtain crude ginkgolic acid.
Crude ginkgolic acid was purified using AB-8 macroporous resin and silica gel column chromatography, followed by analysis using high-performance liquid chromatography (HPLC). In brief, ginkgolic acid standard and purified ginkgolic acid (5 mg) were dissolved separately in anhydrous methanol (1 mL) and filtered through a 0.2 μm syringe filter. The ginkgolic acid was analysed by HPLC (2695E; Waters, Massachusetts, USA) using a C18 chromatographic column (4.6 mm × 250 mm, 5 μm) (Agilent, California, USA), a method described by Lei et al. (2014) with slight modifications. Various concentrations of ginkgolic acid were prepared before the following experiments.
The purified ginkgolic acid sample was mixed with KBr under vacuum, ground and pressed into tablets, and the infrared spectrum was scanned in the range of 4,000–400 cm-1.
Fungistatic rate was measured by radial growth assay with slight modifications (Tan et al., 2017). A medium containing mycelium with a diameter of 5 mm was taken from the same circumference of the edge of the pre-cultured colony by a puncher. Various concentrations of ginkgolic acid were added to the medium (2 mL · 100 mL-1 medium). Then, the colony was cultured in PDA medium with ginkgolic acid (0 mg · mL-1, 2.5 mg · mL-1, 5 mg · mL-1, 10 mg · mL-1) at 30 °C; ginkgolic acid showed an inhibitory effect in this range. Ginkgolic acid was dissolved in 80% ethanol; so the trial with 80% ethanol instead of ginkgolic acid was used as a control. When the colony in the control group grew close to the plate wall, the diameter of a single colony was measured, and the fungistatic rate was calculated according to the following equation:
The effect of ginkgolic acid on the cell membrane of N. oryzae was investigated using an optical microscope. N. oryzae was inoculated in potato dextrose liquid medium with or without ginkgolic acid treatment. It was then placed under an optical microscope (10 × 40) for observation.
N. oryzae was inoculated in potato dextrose liquid medium and cultured at 28 °C for 3 d on a rotary shaker at 150×g. Mycelium (3 g; wet weight) was obtained from the above mixture using a sterile inoculator, dried with sterile filter paper and transferred into 100 mL potato dextrose liquid medium. After sub-culturing at 28 °C with shaking at 150×g for 3 d, ginkgolic acid was added and N. oryzae was cultured in the presence of ginkgolic acid (5 mg · mL-1) for subsequent experiments. Ethanol (80%) was used in the trial as a control instead of ginkgolic acid.
The mycelium of N. oryzae was inoculated into 100 mL liquid medium, to which 5 mg · mL-1 ginkgolic acid solution was added. N. oryzae was cultured in shake flasks (150×g) at 28 °C for 0 h, 2 h, 4 h, 6 h, 8 h, 12 h, 24 h, 30 h, 48 h and 55 h in the media supplemented with ginkgolic acid. The conductivity of the medium was measured using a conductivity meter (DDS-307A; Yoke Instrument Co., Shanghai, China) to analyse the changing trend of cell membrane permeability (Xu et al., 2003).
At 0 h, 3 h, 6 h, 9 h, 12 h, 24 h and 48 h, respectively, 1 g of mycelium was obtained from the mixed culture in which ginkgolic acid was added. The mycelium was thoroughly ground in a mortar containing a small amount of quartz sand and phosphate buffer saline (PBS), and the mixture was collected and put into a centrifuge tube. After centrifugation at a speed of 4,000×g for 10 min, the supernatant was transferred into a colorimetric tube whose specification was 10 mL, diluted with PBS to the specified scale and mixed well.
We then put 1 mL of the diluted solution into a test tube and added 4 mL of Coomassie brilliant blue G-250 reagent. The mixture was allowed to react for 2 min and then the absorbance was measured at 595 nm (Asryants et al., 1985).
Mycelium (1 g) was obtained from the liquid medium of N. oryzae treated with ginkgolic acid for 0 h, 3 h, 6 h, 9 h, 12 h, 24 h and 48 h. After the mycelium was thoroughly ground, the activities of SOD and CAT were measured using the enzyme-linked immunosorbent assay (ELISA) test kit.
The enzyme activity of SOD is calculated as the amount of enzyme that inhibits the auto-oxidation rate of hydroquinone up to 50% per minute in 1 mL of the reaction liquid. The unit enzyme activity of CAT is defined as the amount of 1 μmol H2O2 decomposed per gram of sample per second.
E. aureum (Family: Araceae) with green leaves (>6 cm in diameter) was cultivated as an ornamental plant, which was planted in the plantation of the Dalian Polytechnic University for >3 years.
Spore suspensions were prepared by scraping spores from PDA cultures of N. oryzae using a sterile inoculator and suspending them in sterile distilled water. Spore concentrations were adjusted to 106 colony-forming units (CFU) · mL-1 assisted by the haemocytometer.
Leaves of similar size and no obvious mechanical damage were selected from healthy E. aureum and disinfected with 0.1% sodium hypochlorite for 1 min, washed with sterile water and cultured at room temperature (20 °C).
A sterilised scalpel was used to make a uniform wound (1 mm × 1 mm) in the same position on each blade. The wound site was inoculated with 10 μL sterile distilled water or N. oryzae spore suspension (106 CFU · mL-1). After 3 d of incubation at room temperature, 20 μL sterile distilled water or ginkgolic acid (5 mg · mL-1) was inoculated at the wound site. Leaves were cultured at room temperature for 20 d after being treated as described.
In this paper, all experiments were performed in triplicate. The obtained data were subjected to one-way analysis of variance (ANOVA) using Statistical Package for the Social Sciences (SPSS, version 16.0, Chicago, USA); p < 0.05 was regarded as statistically significant.
The HPLC spectrum of ginkgolic acid was analysed. The results revealed that the purity of ginkgolic acid was 69.18% and it was composed of five ginkgolic acids, that is, C13:0, C15:1, C17:2, C15:0 and C17:1, and their derivatives. The peak area of purified ginkgolic acid was 710.74 mAU*s. The content of C15:1 was the highest, accounting for 38.53% of the purified substance and 55.70% of the total purified ginkgolic acid (Figure 1).

HPLC chromatogram of the standard substance mixture and purified ginkgolic acid. Standard samples are indicated by the black line and by the red line for purified ginkgolic acid by the red line. HPLC, high-performance liquid chromatography.
The infrared spectrum of ginkgolic acid was determined by the KBr tablet method; the results are shown in Figure 2, and the main characteristic peaks are assigned in Table 1. It can be seen from the spectrum that there were multiple absorption peaks at 3,426.36 cm-1, 2,925.45 cm-1, 1,718.90 cm-1, 1,626.12 cm-1, 1,484.59 cm-1, 1,077.92 cm-1, 818.20 cm-1 and 778.24 cm-1.

Infrared spectrum of ginkgolic acid.
The wavenumber of ginkgolic acid.
| Wavenumber, cm−1 | Main characteristic peak assignment | The group |
|---|---|---|
| 3,426.36 | O–H stretching vibration | −OH |
| 2,925.45 | C–H stretching vibration | −CH3 |
| 1,718.90 | C=O stretching vibration | −C=O |
| 1,626.12 | Aromatic ring – C=C stretching vibration | Benzene ring |
| 1,484.59 | Aromatic ring – C=C stretching vibration | Benzene ring |
| 1,077.92 | C–O stretching vibration | −C–OH |
| 818.20 | Aromatic ring =C–H plane bending vibration | −C–H |
| 778.24 | Aromatic ring =C–H plane bending vibration | −C–H |
The experiment results showed that various concentrations of ginkgolic acid had different inhibitory effects on the pathogens. With an increase in concentration, ginkgolic acid showed a similar inhibitory trend to N. oryzae and A. alternata; the inhibition was the strongest at the concentration of 5 mg · mL-1, and the inhibition rates against N. oryzae and A. alternata reached 65.82% and 56.96%, respectively. In addition, it exhibited the highest inhibitory activity against N. oryzae and no significant inhibitory effect on P. expansum (Table 2). So, further research on the effect of ginkgolic acid against N. oryzae was conducted in the study.
Inhibition of fungi by ginkgolic acid.
| Species | Control | Concentration of ginkgolic acid | ||
|---|---|---|---|---|
| 2.5 mg · mL-1 | 5 mg · mL-1 | 10 mg · mL-1 | ||
| Fungistatic rate, % | ||||
| Nigrospora oryzae | 0.792 ±0.023 | 62.032 ±0.056 | 65.822 ±0.032 | 65.291 ±0.028 |
| Penicillium expansum | 2.883 ±0.021 | 2.891 ±0.048 | 3.041 ±0.043 | 3.044 ±0.031 |
| Alternaria alternata | 1.271 ±0.019 | 49.374 ±0.052 | 56.963 ±0.029 | 55.563 ±0.052 |
Therefore, according to the results from Figure 3, the inhibitory action of ginkgolic acid at a concentration of 5 mg · mL-1 against N. oryzae was studied.
Growth status of Nigrospora oryzae on PDA medium with 80% ethanol and different concentrations of ginkgolic acid (0 mg · mL-1, 2.5 mg · mL-1, 5 mg · mL-1 and 10 mg · mL-1). PDA, potato dextrose agar.
The untreated N. oryzae showed an intact cell membrane structure when observed under an optical microscope (Figure 4A). However, after being treated with ginkgolic acid, a blurred cell membrane and intracellular material leakage were observed under the optical microscope (Figure 4B).

Optical microscopic images (10 × 40) of cell membranes of Nigrospora oryzae cultured (A) without and (B) with ginkgolic acid.
The extracellular conductivity was measured to evaluate the cell membrane permeability of N. oryzae. The effect of ginkgolic acid on the electrical conductivity of N. oryzae is shown in Figure 5A. After adding ginkgolic acid, the conductivity of the sample increased significantly between 0 h and 2 h, decreased slightly after 6 h and then stabilised at a high level. Electrical conductivity of the control group showed a general downward trend; although it rose during the period of 0–4 h and reached the peak at the fourth hour, it never exceeded that of the treatment group.

Effect of ginkgolic acid on electrical conductivity (A) and mycelial protein (B) of Nigrospora oryzae.Vertical lines represent standard errors of three replicates. Statistical analysis was performed using t-test at p < 0.05.
For the treatment group, the protein content in the mycelia fell significantly between 0 h and 12 h and then remained stable at an extremely low level. However, in the control group, the protein content in N. oryzae increased slightly within 6 h of co-culture, and there was no significant change after 6 h. In addition, the protein content in the treatment group was much lower than that in the control group (Figure 5B).
As shown in Figure 6A, the activity of SOD in the treatment group first rose sharply from 0 h to 3 h, then declined rapidly until 10 h and finally, it remained stable. In the control group, the overall trend of enzyme activity was up slightly. After treatment for 6 h, SOD activity in the treatment group was significantly lower than that in the control group.

Effect of ginkgolic acid on the activities of (A) SOD and (B) CAT in Nigrospora oryzae. Each value is the mean of three experiments. Bars represent the standard error of the mean. Statistical analysis was performed using t-test at p < 0.05. CAT, catalase; SOD, superoxide dismutase.
Effect of ginkgolic acid on the activity of CAT in N. oryzae is shown in Figure 6B. CAT activity increased significantly from 0 h to 3 h and peaked at the sixth hour, then decreased rapidly between 6 h and 9 h and finally dropped slowly. In the control group, CAT almost remained at the same level after rising, and CAT activity was significantly higher than that in the treatment group after 6 h.
Leaves of E. aureum were infected by N. oryzae and cultured at room temperature for 20 d (Figure 7). The results showed that ginkgolic acid slowed down the disease symptoms. The degree of disease on the leaves is shown in Figure 8. After infection with N. oryzae spore suspension, leaves treated with sterile distilled water had sub-circular brown spots around the wounds with black dotted grains around the spot margins, while leaves treated with ginkgolic acid showed significantly less morbidity and no black dotted grains around the spot margins. Similarly, after mechanical damage, leaves treated with sterile distilled water showed slight lesions around the wound. On the other hand, the wound healed well after treatment with ginkgolic acid.

Protection of leaves by ginkgolic acid. (A) treatment with sterile distilled water after Nigrospora oryzae inoculation; (B) treatment with ginkgolic acid after N. oryzae inoculation; (C) treatment with sterile distilled water after inoculation with sterile distilled water; (D) treatment with ginkgolic acid after inoculation with sterile distilled water. The concentration of spore suspension used for inoculation was 106 CFU · mL-1, and the concentration of ginkgolic acid was 5 mg · mL-1. CFU, colony-forming units.

Degree of leaf disease: (A) treatment with sterile distilled water after Nigrospora oryzae inoculation; (B) treatment with ginkgolic acid after N. oryzae inoculation; (C) treatment with sterile distilled water after inoculation with sterile distilled water; (D) treatment with ginkgolic acid after inoculation with sterile distilled water. The concentration of spore suspension used for inoculation was 106 CFU · mL-1, and the concentration of ginkgolic acid was 5 mg · mL-1. CFU, colony-forming units.
AB-8 macroporous resin has been widely used in the purification of active substances in plants due to its excellent selectivity in the adsorption of some weak polar organic molecules in the solution system (Gao et al., 2013; Zhao et al., 2013). Silica gel chromatography can separate substances according to their polarity and has been used in the isolation of a large number of compounds (Zhao et al., 2016). It has been reported that among the constituents in the alcohol extracts of the testa of G. biloba, the main weak polar compounds with bioactivity are ginkgolic acid, ginkgolic flavonoid and ginkgolide (Zhao, 2013; Wang and Zhang, 2019). Ginkgolides have no obvious inhibitory effect on fungi, and ginkgolic flavonoids can only inhibit the growth of fungi at a very high concentration (≥70 mg · mL-1); so they do not have an impact on this experiment (Fan, 2017).
From the spectrum chart, it can be seen that there are absorbers at 1,626.12 cm-1 and 1,484.59 cm-1, which are characteristic peaks of the vibration of the aromatic ring skeleton. Combined with the absorption peaks at 818.20 cm-1 and 778.24 cm-1 in the fingerprint region, it can be basically determined that there is an aromatic ring in the molecule. The absorption peaks at 2,925.45 cm-1 prove the presence of alkyl groups in the molecule. The absorption peak at 3,426.36 cm-1 proves the existence of phenolic hydroxyl groups in the molecule. The absorption peak at 1,718.90 cm-1 proves the existence of carbonyl groups. However, most of the functional groups generally move to low wavenumbers, which is caused by the conjugation effect of (i) the carbonyl group in the carboxyl group directly connected to the benzene ring and (ii) the molecular hydrogen bond (Swamy et al., 2007).
Ginkgolic acid has been verified to have inhibitory activities on Gram-positive bacteria (Yang et al., 2004a, 2004b). In addition, a literature survey revealed that ginkgolic acid exhibited an inhibitory effect on many common pathogenic fungi infecting vegetables (Lin et al., 2010). Similarly, in the current study, ginkgolic acid inhibited the growth and reproduction of N. oryzae, A. alternata and P. expansum to different degrees. The radial growth assay is a commonly used method to test the inhibition of fungal substances (Cruz et al., 2019).
During the growth phase, microorganisms use nutrients, such as mineral salt, in the culture medium. In general, the conductivity of the medium will decline with the extension of microbial culture time. However, when a microbe is destroyed, the permeability of the cell membrane will increase, and small molecules such as inorganic salts in the cells leak out, resulting in an increase in the conductivity of the liquid medium. Therefore, the change of cell membrane permeability can be evaluated by the conductivity in the culture medium (Shen et al., 2015). As shown in Figure 5A, the conductivity of the treatment group with ginkgolic acid increased significantly from 0 h to 2 h, indicating that ginkgolic acid damaged N. oryzae and increased its membrane permeability. The reason why conductivity declined slightly at the sixth hour was that the activity of CAT reached its peak at this time point (as described later on). It caused the stress reaction in N. oryzae and protected the damaged cell membrane. And then the conductivity tended to be stable. It indicated that under the action of ginkgolic acid, the growth metabolism of N. oryzae became slow or stopped, resulting in no change of the conductivity, and no utilisation of inorganic salt ions and other nutrients in the culture medium (Pavlin et al., 2005).
The stability of the cell membrane is mainly related to the hydrophobic interaction. After the hydrophobic core in the membrane structure is destroyed, the polarity of this region will be enhanced, and the osmotic balance of polar molecules will be disturbed, leading to the loss of membrane integrity. Previous reports have demonstrated that some compounds that inhibit microbial growth, such as antimicrobial peptides, interact with the hydrophobic groups in the lipid bilayer of the pathogen’s cell membrane to exert their antibacterial activity (Oren et al., 1997; Yan et al., 2003). Ginkgolic acid is a small hydrophobic molecule. In this study, the cell membrane of N. oryzae treated with ginkgolic acid was ruptured. Our hypothesis is that ginkgolic acid penetrated the cell wall of N. oryzae and interacted with the hydrophobic groups on the cell membrane, thereby damaging the cell membrane structure. So the interaction between ginkgolic acid and hydrophobic groups will be studied further.
The intracellular protein content of the treatment group decreased, implying that ginkgolic acid could cause a large amount of protein leakage out of the mycelia or directly lead to mycelial protein degeneration. Furthermore, ethanol, a common solution used for disinfection because it dehydrates microbial proteins, had no obvious effect on the mycelial protein content of N. oryzae at low doses. After treatment for 12 h, the change in protein content tended to be stable. It could be inferred as mycelium protein denaturation or mass leakage, leading to the death of the fungus. Studies have shown that antifungal substances acting on the cell membrane can cause protein leakage in the mycelium (Kumari et al., 1994; Zhang et al., 2011). According to the above results, we deduced that the inhibitory effect of ginkgolic acid on N. oryzae was related to the destruction of the cell membrane, resulting in osmotic imbalance, leading to the leakage of cell components and, ultimately, to cell death.
SOD catalyses the dismutation of superoxide anion free radicals, thus eliminating harmful substances in the metabolic process and protecting the microorganism from damage (Powers et al., 2008; Zhang et al., 2011). From 0 h to 3 h, N. oryzae in the treatment group responded to the stress of ginkgolic acid and increased the activity of SOD to protect the biome. After 3 h, the enzyme activity began to decline.
According to the results shown in Figure 6A, it can be inferred that ginkgolic acid destroyed the biomembrane integrity, increased its permeability and caused the leaking out of a large amount of proteins and other substances from the cell. This resulted in the weakened resistance to external adversity and the weakened activity of SOD in N. oryzae (Ron, 2002).
CAT can eliminate H2O2, which is generated in a disproportion reaction, and eventually produces H2O and O2, thus protecting cells from damage. It is one of the key enzymes of the biological defence system (Ortiz et al., 2013).
At the beginning, in order to protect microorganisms under stress, the activity of CAT showed an upward trend and reached its peak at the sixth hour. Subsequently, because of the serious cell damage in the treatment group, the CAT activity of N. oryzae in the treatment group began to decrease. The loss of enzyme activity resulted in the situation that H2O2 produced in the disproportionation reaction could not be completely and effectively eliminated. It proved that ginkgolic acid had an inhibitory effect on N. oryzae. However, low doses of ethanol could not decrease the activity of CAT or effectively inhibit the growth of N. oryzae.
Ginkgolic acid effectively reduced damage in leaves infected by N. oryzae. So, ginkgolic acid can protect the leaves from infection by N. oryzae and facilitate the growth of plants. The inhibitory trend of ginkgolic acid on N. oryzae was similar in both leaf and agar plate. The difference in details is due to the conditions on the leaf being different from those on the agar plate (Zhao et al., 2012). Similarly, it was reported by Zhao (2013) that the extracts of G. biloba testa affected cabbage seed germination, promoting growth at low concentrations and inhibiting growth at high concentrations.
In this study, the antifungal action of ginkgolic acid on N. oryzae, A. alternata and P. expansum was investigated under in vitro conditions. Ginkgolic acid showed different inhibitory effects on these three pathogens and had the strongest inhibitory activities on N. oryzae. Ginkgolic acid increased membrane permeability by destroying the cell membrane of N. oryzae, which then led to leakage of mycelial proteins and other contents and, ultimately, N. oryzae cell death. Ginkgolic acid also reduced the activity of SOD and CAT in N. oryzae, thereby slowing the fungal infection. Moreover, ginkgolic acid showed a protective effect on the leaves of E. aureum after infection by N. oryzae.